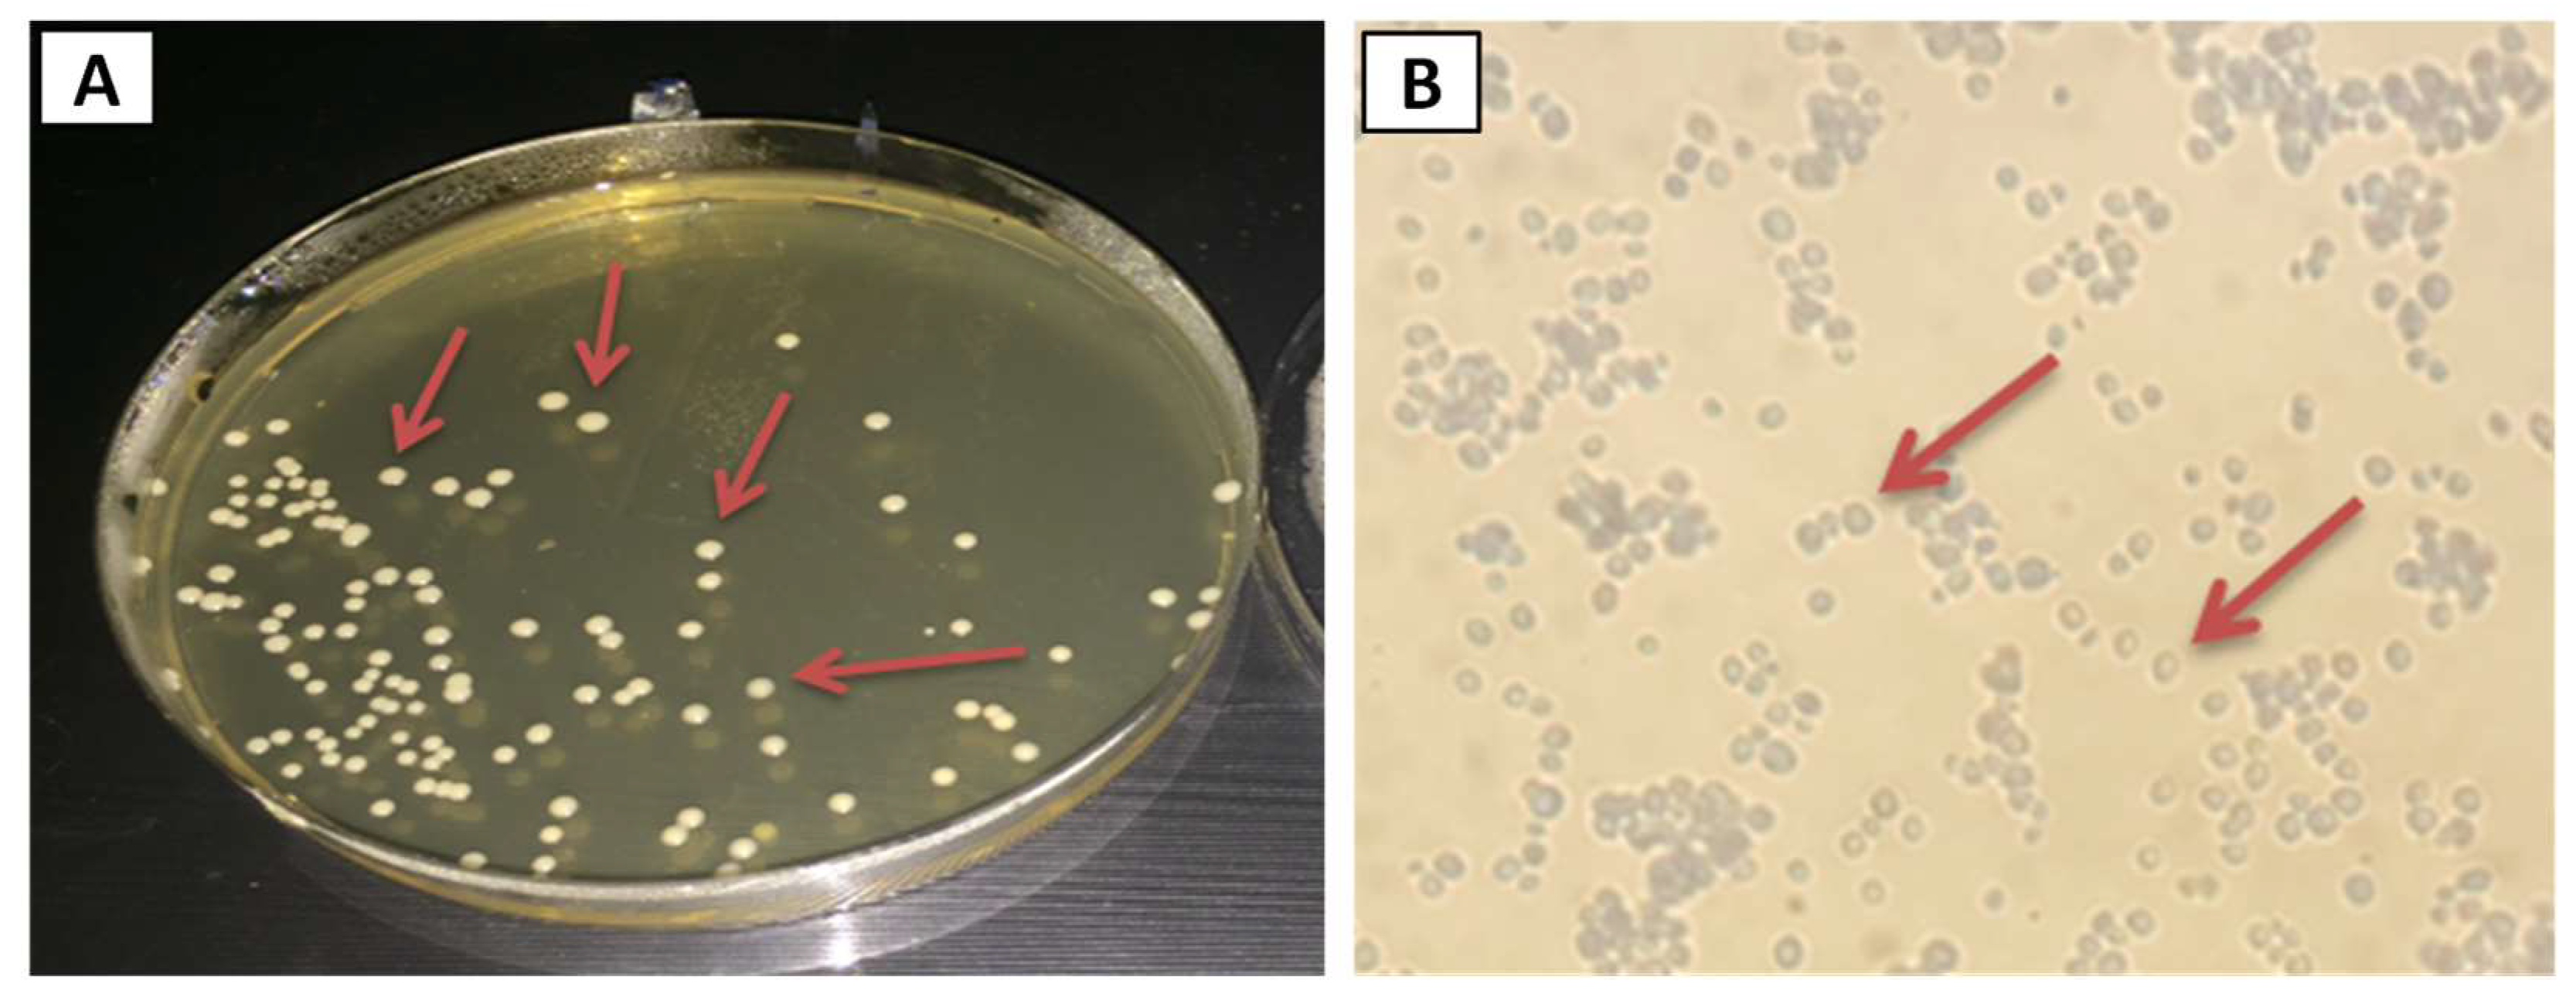
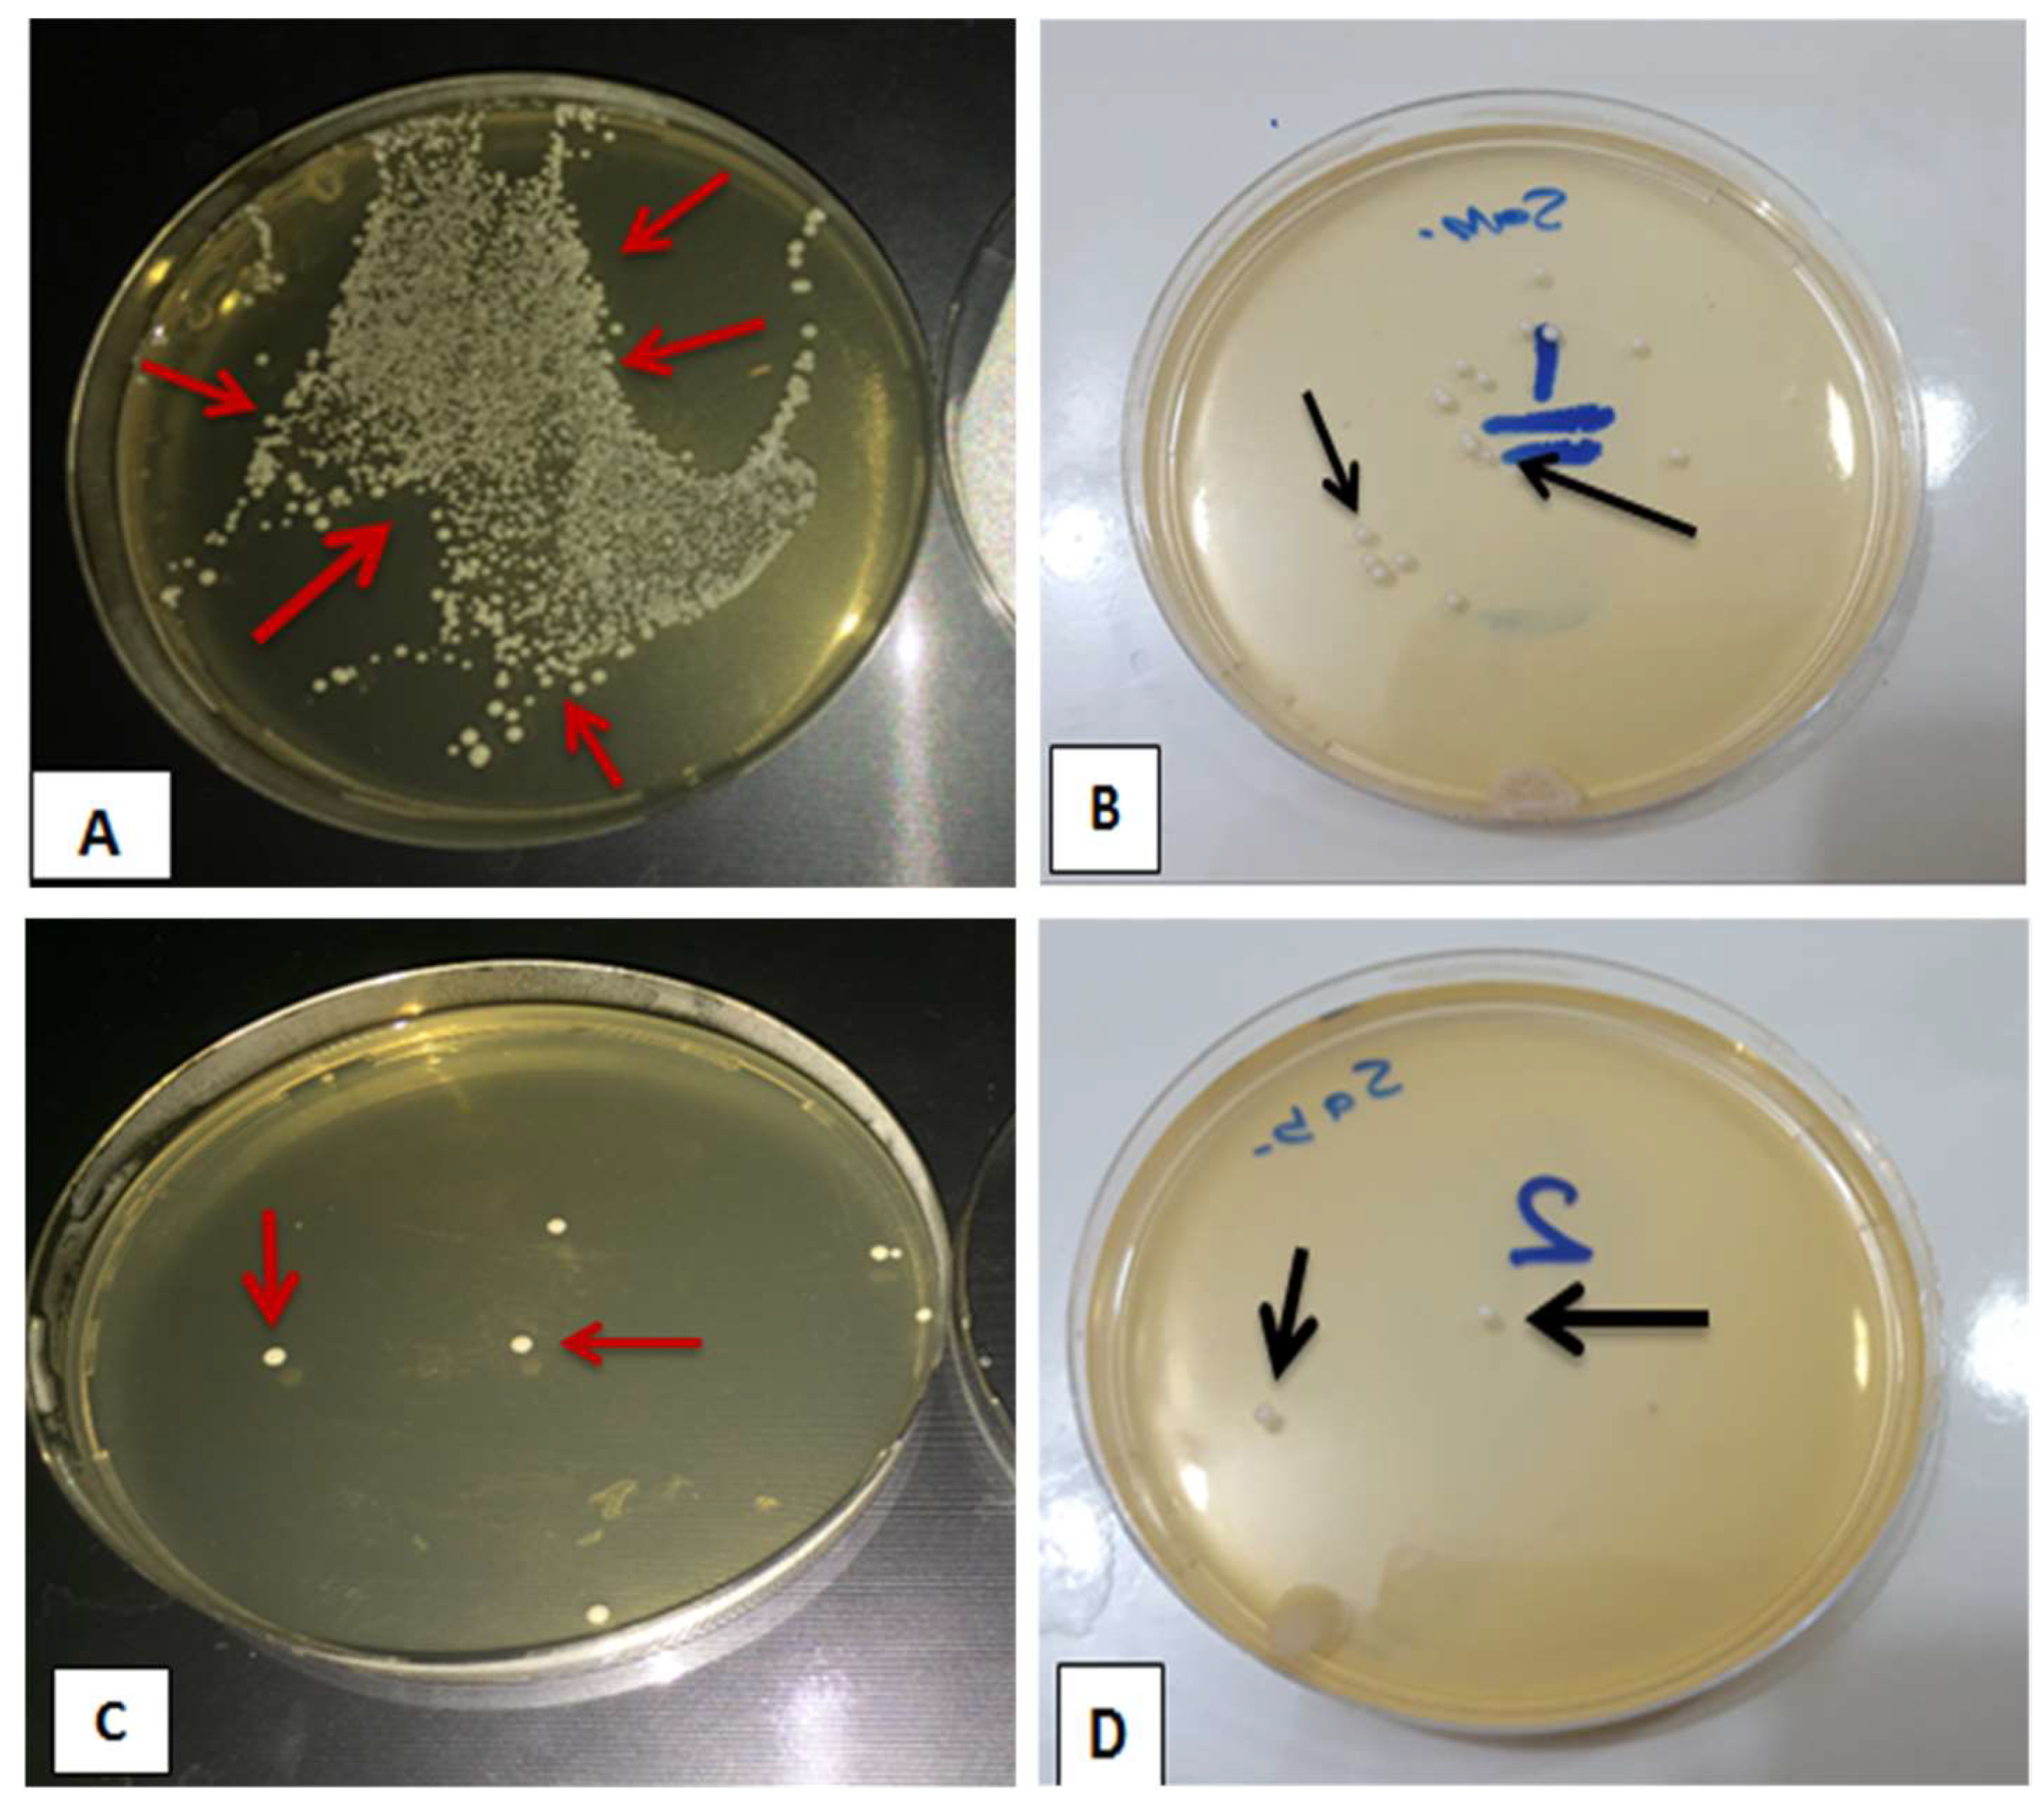

Assessing the Antifungal Activity of a Soft Denture Liner Loaded with Titanium Oxide Nanoparticles (TiO2 NPs)
Abstract
1. Introduction
- The addition TiO2 NPs in the PEMA denture liner would not make any difference in the viable count of C. albicans.
- With increasing the concentration of TiO2 NPs in PEMA, the viable count of C. albicans would not be affected.
2. Materials and Methods
2.1. Materials
2.2. Fabrication of Soft Liner Samples
2.2.1. Mold Preparation
2.2.2. Preparing Heat Cure PEMA Soft Liner
2.2.3. Incorporation of Titanium Nanoparticles
2.3. Isolation of Candida albicans
2.4. Identification of Candida albicans
2.4.1. Colony Morphology and Microscopical Observation
2.4.2. Germ Tube Formation
2.4.3. Biochemical Identification
2.5. Assessing Antifungal Activity of PEMA-TiO2 Nanocomposites
2.6. Characterization of Soft Liner Samples
2.7. Statistical Analysis
3. Results
3.1. Nano-Composite Characteristics
3.2. Evaluating Viable Count of C. albicans (CFU/mL)
4. Discussion
5. Conclusions
- (1)
- Microstructural analyses demonstrated uniform dispersion of TiO2 NPs in the PEMA polymeric matrix.
- (2)
- Antifungal properties can be embedded within the soft denture lining material with the addition of TiO2 NPs into PEMA.
- (3)
- The antifungal efficacy was found to be concentration dependent, with an increased antifungal activity when there was an increase in the concentration of TiO2 NPs.
- (4)
- A concentration ranging from 1.0 to 2.0 wt.% TiO2 NPs in the PEMA denture liner could significantly reduce C. albicans colony formation in the oral environment compared with pure PEMA.
Author Contributions
Funding
Institutional Review Board Statement
Informed Consent Statement
Data Availability Statement
Acknowledgments
Conflicts of Interest
References
- Kranjčić, J.; Kostelić-Stunić, M.; Čelebić, A.; Komar, D.; Mehulić, K.; Vojvodić, D. Denture relining as an indicator of residual ridge resorption. Med. Glas. 2013, 10, 126–132. [Google Scholar]
- Imirzalioglu, P.; Karacaer, O.; Yilmaz, B.; Ozmen MSc, I. Color stability of denture acrylic resins and a soft lining material against tea, coffee, and nicotine. J. Prosthodont. 2010, 19, 118–124. [Google Scholar] [CrossRef]
- Mahajan, N.; Datta, K. Comparison of bond strength of auto polymerizing, heat cure soft denture liners with denture base resin—An In Vitro study. J. Indian Prosthodont. Soc. 2010, 10, 31–35. [Google Scholar] [CrossRef]
- Bulad, K.; Taylor, R.L.; Verran, J.; McCord, J.F. Colonization and penetration of denture soft lining materials by Candida albicans. Dent. Mater. 2004, 20, 167–175. [Google Scholar] [CrossRef]
- Ergun, G.; Nagas, I.C. Color stability of silicone or acrylic denture liners: An in vitro investigation. Eur. J. Dent. 2007, 1, 144–151. [Google Scholar] [CrossRef]
- Rao, C.S.; Reddy, S.S.; Prasad, G.M.; Reddy, K.S.; Rao, N.V.; Naik, M.S. A study to evaluate and compare the shear bond strength of resilient liners with heat cure denture base resins, with and without the effect of saliva: An in vitro study. J. Contemp. Dent. Pract. 2012, 13, 394–400. [Google Scholar]
- Pavan, S.; Arioli Filho, J.N.; Dos Santos, P.H.; Nogueira, S.S.; Batista, A.U.D. Effect of disinfection treatments on the hardness of soft denture liner materials. J. Prosthodont. 2007, 16, 101–106. [Google Scholar] [CrossRef]
- Chladek, G.; Kasperski, J.; Barszczewska-Rybarek, I.; Żmudzki, J. Sorption, solubility, bond strength and hardness of denture soft lining incorporated with silver nanoparticles. Int. J. Mol. Sci. 2013, 14, 563–574. [Google Scholar] [CrossRef]
- Krishnamurthy, S.; Hallikerimath, R.B. An in-vitro evaluation of retention, colonization and penetration of commonly used denture lining materials by candida albicans. J. Clin. Diagn. Res. JCDR 2016, 10, ZC84. [Google Scholar] [CrossRef]
- Coronado-Castellote, L.; Jiménez-Soriano, Y. Clinical and microbiological diagnosis of oral candidiasis. J. Clin. Exp. Dent. 2013, 5, e279–e286. [Google Scholar] [CrossRef]
- Byadarahally Raju, S.; Rajappa, S. Isolation and identification of Candida from the oral cavity. ISRN Dent. 2011, 2011, 487921. [Google Scholar] [CrossRef]
- Nazirkar, G.; Bhanushali, S.; Singh, S.; Pattanaik, B.; Raj, N. Effect of anatase titanium dioxide nanoparticles on the flexural strength of heat cured poly methyl methacrylate resins: An in-Vitro Study. J. Indian Prosthodont. Soc. 2014, 14, 144–149. [Google Scholar] [CrossRef]
- Nam, K.Y. In vitro antimicrobial effect of the tissue conditioner containing silver nanoparticles. J. Adv. Prosthodont. 2011, 3, 20–24. [Google Scholar] [CrossRef] [PubMed]
- Al-Shammari, R.S.S.; Jaberi, A.K.H.; Lungu, A.; Brebenel, I.; Al-Sudani, W.K.K.; Al-Saedi, J.H.M.; Pop, C.-E.; Mernea, M.; Stoian, G.; Mihailescu, D.F. The Antifungal Activity of Zein Nanoparticles Loaded With Transition Metal Ions. Rev. Roum. Chim. 2021, 66, 829–834. [Google Scholar]
- Lara, H.H.; Romero-Urbina, D.G.; Pierce, C.; Lopez-Ribot, J.L.; Arellano-Jiménez, M.J.; Jose-Yacaman, M. Effect of silver nanoparticles on Candida albicans biofilms: An ultrastructural study. J. Nanobiotechnology 2015, 13, 1–12. [Google Scholar] [CrossRef]
- Iqbal, Z.; Zafar, M.S. Role of antifungal medicaments added to tissue conditioners: A systematic review. J. Prosthodont. Res. 2016, 60, 231–239. [Google Scholar] [CrossRef] [PubMed]
- Dizaj, S.M.; Lotfipour, F.; Barzegar-Jalali, M.; Zarrintan, M.H.; Adibkia, K. Antimicrobial activity of the metals and metal oxide nanoparticles. Mater. Sci. Eng. C 2014, 44, 278–284. [Google Scholar] [CrossRef]
- Nadeem, M.; Tungmunnithum, D.; Hano, C.; Abbasi, B.H.; Hashmi, S.S.; Ahmad, W.; Zahir, A. The current trends in the green syntheses of titanium oxide nanoparticles and their applications. Green Chem. Lett. Rev. 2018, 11, 492–502. [Google Scholar] [CrossRef]
- George, S.A.; Raj, M.S.; Solomon, D.; Roselin, P. Comparative study of the anti-fungal activity of zinc oxide and titanium dioxide nano and bulk particles with anti-fungals against fungi isolated from infected skin and dandruff flakes. Res. Rev. J. Microbiol. Biotechnol. 2014, 3, 23–30. [Google Scholar]
- Ahmed, M.A.; El-Shennawy, M.; Althomali, Y.M.; Omar, A.A. Effect of titanium dioxide nano particles incorporation on mechanical and physical properties on two different types of acrylic resin denture base. World J. Nano Sci. Eng. 2016, 6, 111–119. [Google Scholar] [CrossRef]
- Elshereksi, N.W.; Ghazali, M.J.; Muchtar, A.; Azhari, C.H. Perspectives for titanium-derived fillers usage on denture base composite construction: A review article. Adv. Mater. Sci. Eng. 2014, 2014, 746252. [Google Scholar] [CrossRef]
- Sun, J.; Forster, A.M.; Johnson, P.M.; Eidelman, N.; Quinn, G.; Schumacher, G.; Zhang, X.; Wu, W.L. Improving performance of dental resins by adding titanium dioxide nanoparticles. Dent. Mater. 2011, 27, 972–982. [Google Scholar] [CrossRef]
- Chladek, G.; Mertas, A.; Barszczewska-Rybarek, I.; Nalewajek, T.; Zmudzki, J.; Krol, W.; Lukaszczyk, J. Anti -fungal Activity of Soft Lining Material Modified by Silver Nanoparticles—A Pilot study. Int. J. Mol. Sci. 2011, 12, 4735–4744. [Google Scholar] [CrossRef]
- Axéll, T.; Simonsson, T.; Birkhed, D.; Rosenborg, J.; Edwardsson, S. Evaluation of a simplified diagnostic aid (Oricult-N) for detection of oral candidoses. Scand. J. Dent. Res. 1985, 93, 52–55. [Google Scholar] [CrossRef]
- Marler, L.M.; Siders, J.A.; Allen, S.D. Direct Smear Atlas: A Monograph of Gram-Stained Preparations of Clinical Specimens; Lippincott Williams & Wilkins: Philadelphia, PA, USA, 2001. [Google Scholar]
- Monteiro, D.R.; Gorup, L.F.; Takamiya, A.S.; de Camargo, E.R.; Ruvolo Filho, A.C.; Barbosa, D.B. Silver Distribution and Release from an Antimicrobial Denture Base Resin Containing Silver Colloidal Nanoparticles. J. Prosthodont. 2011, 21, 7–15. [Google Scholar] [CrossRef] [PubMed]
- Ahmed, A.Q.; Ali, M.M.M. The influence of titanium dioxide nanoparticles incorporation into soft denture lining material on Candida albicans adherence and some mechanical and physical properties. J. Pure Appl. Microbiol. 2018, 12, 783–791. [Google Scholar] [CrossRef]
- Kimoto, S.; Kimoto, K.; Murakami, H.; Gunji, A.; Ito, N.; Kawai, Y. Survival analysis of mandibular complete dentures with acrylic-based resilient liners. Gerodontology 2013, 30, 187–193. [Google Scholar] [CrossRef]
- Mancuso, D.N.; Goiato, M.C.; Zuccolotti, B.C.R.; Moreno, A.; dos Santos, D.M.; Pesqueira, A.A. Effect of thermocycling on hardness, absorption, solubility and colour change of soft liners. Gerodontology 2012, 29, e215–e219. [Google Scholar] [CrossRef]
- Akin, H.; Tugut, F.; Mutaf, B.; Akin, G.; Ozdemir, A.K. Effect of different surface treatments on tensile bond strength of silicone-based soft denture liner. Lasers Med. Sci. 2011, 26, 783–788. [Google Scholar] [CrossRef]
- Akhtar, S.; Ali, I.; Tauseef, S.; Ahmed, F.; Shuja, A.; Sherwani, S.K. Synthesis, characterization and antibacterial activity of titanium dioxide (TiO2) nanoparticles. Fuuast J. Biol. 2016, 6, 141–147. [Google Scholar]
- Durairaj, B.; Muthu, S.; Xavier, T. Antimicrobial activity of Aspergillus niger synthesized titanium dioxide nanoparticles. Adv. Appl. Sci. Res. 2015, 6, 45–48. [Google Scholar]
- Zhang, H.; Li, Q.; Lu, Y.; Sun, D.; Lin, X.; Deng, X.; He, N.; Zheng, S. Biosorption and bioreduction of diamine silver complex by Corynebacterium. J. Chem. Technol. Biotechnol. 2005, 80, 285–290. [Google Scholar] [CrossRef]
- Abass, A.A.; Abdulridha, W.M.; Alaarage, W.K.; Abdulrudha, N.H.; Haider, J. Evaluating the antibacterial effect of cobalt nanoparticles against multi-drug resistant pathogens. J. Med. Life 2021, 14, 823–833. [Google Scholar] [CrossRef]
- Haghighi, F.; Roudbar Mohammadi, S.; Mohammadi, P.; Hosseinkhani, S.; Shipour, R. Antifungal activity of TiO2 nanoparticles and EDTA on Candida albicans biofilms. Infect. Epidemiol. Med. 2013, 1, 33–38. [Google Scholar]
- Kamikawa, Y.; Hirabayashi, D.; Nagayama, T.; Fujisaki, J.; Hamada, T.; Sakamoto, R.; Kamikawa, Y.; Sugihara, K. In vitro antifungal activity against oral Candida species using a denture base coated with silver nanoparticles. J. Nanomater. 2014, 2014, 780410. [Google Scholar] [CrossRef]
- Alhotan, A.; Yates, J.; Zidan, S.; Haider, J.; Silikas, N. Flexural Strength and Hardness of Filler-Reinforced PMMA Targeted for Denture Base Application. Materials 2021, 14, 2659. [Google Scholar] [CrossRef] [PubMed]
- Alhotan, A.; Yates, J.; Zidan, S.; Haider, J.; Silikas, N. Assessing Fracture Toughness and Impact Strength of PMMA Reinforced with Nano-Particles and Fibre as Advanced Denture Base Materials. Materials 2021, 14, 4127. [Google Scholar] [CrossRef] [PubMed]
- Alhotan, A.; Elraggal, A.; Yates, J.; Haider, J.; Jurado, C.A.; Silikas, N. Effect of Different Solutions on the Colour Stability of Nanoparticles or Fibre Reinforced PMMA. Polymers 2022, 14, 1521. [Google Scholar] [CrossRef]
- Totu, E.E.; Nechifor, A.C.; Nechifor, G.; Aboul-Enein, H.Y.; Cristache, C.M. Poly (methyl methacrylate) with TiO2 nanoparticles inclusion for stereolitographic complete denture manufacturing—The future in dental care for elderly edentulous patients? J. Dent. 2017, 59, 68–77. [Google Scholar] [CrossRef]
- Waly, G.H. Effect of incorporating undoped or silver-doped photocatalytic titanium dioxide on the antifungal effect and dynamic viscoelastic properties of long-term acrylic denture liners. Future Dent. J. 2018, 4, 8–15. [Google Scholar] [CrossRef]
- Azmy, E.; Alkholy, M.R.; Helal, M.A. Microbiological evaluation for antifungal activity of some metal oxides nanofillers incorporated into cold cured soft lining materials: Clinical based study. Braz. Dent. Sci. 2022, 25, e2921. [Google Scholar] [CrossRef]
- Fadhil Al-Tu’ma, A.; Zaki, Z.D.M.; Ahmed, R.; Abbood, S.K.; Ruhaima, A.A.K.; Hamoodah, Z.J.; Abed, A.S.; Pavlova, I.V. Inhibitory Effect of ZrO2NPs on Candida Albicans in Heat-Cured Acrylic-Based Soft Lining Material. J. Nanostructures 2022, 12, 771–773. [Google Scholar]
- Kulak-Ozkan, Y.; Kazazoglu, E.; Arikan, A. Oral hygiene habits, denture cleanliness, presence of yeasts and stomatitis in elderly people. J. Oral Rehabil. 2002, 29, 300–304. [Google Scholar] [CrossRef] [PubMed]
- Pazokifard, S.; Esfandeh, M.; Mirabedini, S.M.; Mohseni, M.; Ranjbar, Z. Investigating the role of surface treated titanium dioxide nanoparticles on self-cleaning behavior of an acrylic facade coating. J. Coat. Technol. Res. 2013, 10, 175–187. [Google Scholar] [CrossRef]
- AlQahtani, G.M.; AlSuhail, H.S.; Alqater, N.K.; AlTaisan, S.A.; Akhtar, S.; Khan, S.Q.; Gad, M.M. Polymethylmethacrylate denture base layering as a new approach for the addition of antifungal agents. J. Prosthodont. 2022. [Google Scholar] [CrossRef]
- Amano, D.; Ueda, T.; Sugiyama, T.; Takemoto, S.; Oda, Y.; Sakurai, K. Improved brushing durability of titanium dioxide coating on polymethylmethacrylate substrate by prior treatment with acryloxypropyl trimethoxysilane-based agent for denture application. Dent. Mater. J. 2010, 29, 97–103. [Google Scholar] [CrossRef]
- Raju, K.; Natrajan, S.; Krishnamurthy, P. Evaluation of Antimicrobial Efficacy of Titanium Dioxide on Dental Plaque Colonisers: An In-vitro Study. J. Clin. Diagn. Res. 2022, 16, ZC45–ZC48. [Google Scholar] [CrossRef]

| Number | Description | Manufacturer |
|---|---|---|
| 1 | Vertex-soft Polyethyl methacrylate denture liner | Vertex, The Netherlands |
| 2 | Titanium dioxide nanoparticles (TiO2 NPs, anatase structure, 10–30 nm) | SkySpring, USA |
| 3 | Addition Silicone impression material | Vertex, The Netherlands |
| 4 | Type IV Dental stone | Zhermack, Italy |
| 5 | Sabouraud dextrose agar and Sabouraud dextrose broth | Oxoid, UK |
| 6 | API-Candida | BioMérieux, France |
| Sample Groups | Mean | Standard Deviation | Standard Error | 95% Confidence Interval for Mean | Min. | Max. | AFE (%) | |
|---|---|---|---|---|---|---|---|---|
| Lower Bound | Upper Bound | |||||||
| Control (0.0 wt.%) | 139.80 | 18.546 | 5.865 | 126.53 | 153.07 | 101 | 172 | 0.0 |
| 1.0 wt.% | 12.00 | 3.916 | 1.238 | 9.20 | 14.80 | 7 | 18 | 91.42 |
| 1.5 wt.% | 6.20 | 2.394 | 0.757 | 4.49 | 7.91 | 2 | 10 | 95.57 |
| 2 wt.% | 1.00 | 1.054 | 0.333 | 0.25 | 1.75 | 0 | 3 | 99.28 |
| Sum of Squares | df | Mean Square | F | Sig. | |
|---|---|---|---|---|---|
| Between Groups | 134,072.300 | 3 | 44,690.767 | 488.246 | 0.000 |
| Within Groups | 3295.200 | 36 | 91.533 | ||
| Total | 137,367.500 | 39 |
| Samples | Mean Difference (I-J) | Sig. | |
|---|---|---|---|
| Control | 1.0 wt.% | 127.800 * | 0.000 |
| 1.5 wt.% | 133.600 * | 0.000 | |
| 2.0 wt.% | 138.800 * | 0.000 | |
| 1.0 wt.% | 1.5 wt.% | 5.800 | 0.184 |
| 2.0 wt.% | 11.000 * | 0.014 | |
| 1.5 wt.% | 2.0 wt.% | 5.200 | 0.232 |
Disclaimer/Publisher’s Note: The statements, opinions and data contained in all publications are solely those of the individual author(s) and contributor(s) and not of MDPI and/or the editor(s). MDPI and/or the editor(s) disclaim responsibility for any injury to people or property resulting from any ideas, methods, instructions or products referred to in the content. |
© 2023 by the authors. Licensee MDPI, Basel, Switzerland. This article is an open access article distributed under the terms and conditions of the Creative Commons Attribution (CC BY) license (https://creativecommons.org/licenses/by/4.0/).
Share and Cite
Ahmed, A.Q.; Al-Hmedat, S.J.A.-Z.; Hanweet, D.M.; Haider, J. Assessing the Antifungal Activity of a Soft Denture Liner Loaded with Titanium Oxide Nanoparticles (TiO2 NPs). Dent. J. 2023, 11, 90. https://doi.org/10.3390/dj11040090
Ahmed AQ, Al-Hmedat SJA-Z, Hanweet DM, Haider J. Assessing the Antifungal Activity of a Soft Denture Liner Loaded with Titanium Oxide Nanoparticles (TiO2 NPs). Dentistry Journal. 2023; 11(4):90. https://doi.org/10.3390/dj11040090
Chicago/Turabian StyleAhmed, Amal Qasim, Sattar Jabbar Abdul-Zahra Al-Hmedat, Dunya Malhan Hanweet, and Julfikar Haider. 2023. "Assessing the Antifungal Activity of a Soft Denture Liner Loaded with Titanium Oxide Nanoparticles (TiO2 NPs)" Dentistry Journal 11, no. 4: 90. https://doi.org/10.3390/dj11040090
APA StyleAhmed, A. Q., Al-Hmedat, S. J. A.-Z., Hanweet, D. M., & Haider, J. (2023). Assessing the Antifungal Activity of a Soft Denture Liner Loaded with Titanium Oxide Nanoparticles (TiO2 NPs). Dentistry Journal, 11(4), 90. https://doi.org/10.3390/dj11040090

